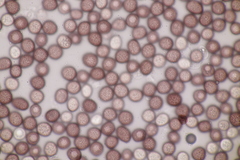
Microbotryum pustulatum
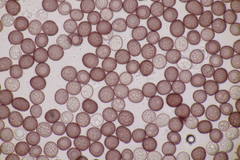
Microbotryum pustulatum
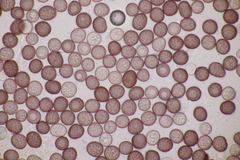
Microbotryum pustulatum

Microbotryum pustulatum: taxon details and analytics
- Domain
- Kingdom
- Fungi
- Phylum
- Basidiomycota
- Class
- Microbotryomycetes
- Order
- Microbotryales
- Family
- Microbotryaceae
- Genus
- Microbotryum
- Species
- Microbotryum pustulatum
- Scientific Name
- Microbotryum pustulatum
Summary description from Wikipedia:
Microbotryum pustulatum
Microbotryum pustulatum är en svampart som först beskrevs av Augustin Pyrame de Candolle, och fick sitt nu gällande namn av R. Bauer & Oberw. 1997. Microbotryum pustulatum ingår i släktet Microbotryum och familjen Microbotryaceae. Inga underarter finns listade i Catalogue of Life.
...Microbotryum pustulatum in languages:
- Finnish
- konnantattarenlehtituhkio
Images from inaturalist.org observations:
We recommend you sign up for this excellent, free service.
Parent Taxon
Sibling Taxa
- Microbotryum anomalum
- Microbotryum bistortarum
- Microbotryum bosniacum
- Microbotryum cardui
- Microbotryum cichorii
- Microbotryum claytoniae
- Microbotryum cordae
- Microbotryum coronariae
- Microbotryum dianthorum
- Microbotryum duriaeanum
- Microbotryum flosculorum
- Microbotryum holostei
- Microbotryum kuehneanum
- Microbotryum lagerheimii
- Microbotryum lychnidis-dioicae
- Microbotryum major
- Microbotryum marginale
- Microbotryum moenchiae-manticae
- Microbotryum nivale
- Microbotryum parlatorei
- Microbotryum pinguiculae
- Microbotryum pustulatum
- Microbotryum reticulatum
- Microbotryum salviae
- Microbotryum saponariae
- Microbotryum scabiosae
- Microbotryum scorzonerae
- Microbotryum silenes-acaulis
- Microbotryum silenes-dioicae
- Microbotryum silenes-inflatae
- Microbotryum silenes-saxifragae
- Microbotryum stellariae
- Microbotryum stygium
- Microbotryum succisae
- Microbotryum superbum
- Microbotryum tenuisporum
- Microbotryum tragopogonis-pratensis
- Microbotryum violaceoirregulare
- Microbotryum violaceoverrucosum
- Microbotryum violaceum